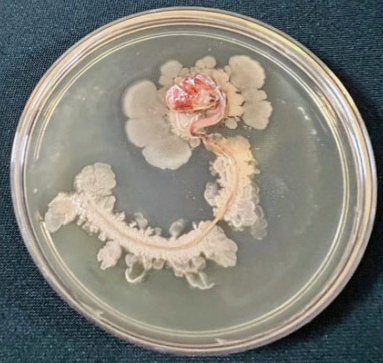

Os nematoides fitopatogênicos, dentre eles, Heterodera glycines (nematoide do cisto da soja), Meloidogyne spp. (nematoide das galhas), Rotylenchulus reniformis (nematoide reniforme) e Pratylenchus brachyurus (nematoide das lesões radiculares), integram o grupo das principais espécies de pragas da cultura da soja. Os danos variam em função da espécie, suscetibilidade da cultivar e densidade populacional da praga, podendo resultar em perdas expressivas de produtividade, ou até mesmo inviabilizando o cultivo.
Dentre os fatores que mais influenciam no desenvolvimento dos fitonematoides em áreas agrícolas, destacam-se temperatura e textura do solo. De modo geral, solos de texturas mais leves (com menor teor de argila), tendem a apresentar condições melhores para o desenvolvimento dos fitonematoides, atrelados a isso, condições de temperaturas na faixa de 29 a 31°C favorecem o desenvolvimento do fitonematoides como o M. javanica (Inomoto & Asmus, 2009).
Por se tratar de pragas de solo, o controle direto dos fitonematoides via aplicação de nematicidas químicos é uma tarefa difícil, ainda mais se tratando de moléculas de baixo efeito residual. Além das boas práticas agronômicas que incluem a rotação de culturas com espécies não hospedeiras e a semeadura de cultivares de soja mais tolerantes, o uso de bioinsumos tem contribuído para o controle dos fitonematoides em áreas agrícolas, reduzindo os danos ocasionados por eles na cultura da soja.
Dentre os microrganismos empregados com esse intuito, destacam-se as bactérias do gênero Bacillus. Conforme relatado por Coelho et al. (2021) e Costa et al. (2019), o uso de bactérias do gênero Bacillus na cultura da soja tem se mostrado uma estratégia promissora tanto para o manejo de fitonematoides, como Pratylenchus brachyurus, quanto para a promoção do crescimento vegetal. Nesse contexto, estirpes de Bacillus, especialmente Bacillus subtilis, aplicadas via tratamento de sementes, contribuem para o incremento da parte aérea e do volume radicular das plantas, destacando-se as doses de 2 e 4 mL de produtos à base de B. subtilis por kg de sementes como as mais eficientes.
Os bionematicidas à base de bactérias, majoritariamente compostos por cepas do gênero Bacillus, lideram o mercado devido à ampla eficácia no controle de nematoides. Seu principal mecanismo de ação é a formação de biofilme no rizoplano, que atua como barreira física ao competir por sítios de penetração, além de liberar enzimas e compostos com efeito nematicida, capazes de afetar ovos e formas infectantes dos nematoides no solo (Dias-Arieira & Santana-Gomes, 2025).
Figura 1. Biofilme oriundo de Bacillus spp. ao redor da semente e da raiz de soja.
Corroborando a eficiência das bactérias do gênero Bacillus no controle dos fitonematoides da soja, Reis e Oliveira (2025) observaram que o tratamento de sementes de soja com Bacillus methylotrophicu reduziu significativamente o número de nematoides Meloidogyne javanica nas raízes das plantas tratadas (figura 2), além de reduzir o número de nematoides por amostra de solo (100 cm³).
Figura 2. Resultados de número de nematoides para 5,0 g de raiz em sementes de soja tratadas com B.methylotrophicus e inoculadas com M. javanica.

Os resultados observados por Reis e Oliveira (2025) demonstram que o tratamento de sementes de soja com Bacillus methylotrophicus, contribui não só para a redução da densidade de nematoides no solo e nas raízes, mas também, para um melhoria da massa fresca de raízes e da parte aérea das plantas tratas, sendo que, os melhores resultados foram obtidos com doses de Bacillus methylotrophicus variando de 0,30 a 0,38 ml.kg de sementes.
Estudos anteriores como o realizado por Araújo; Silva; Araújo (2002) também evidenciam a eficiência do gênero Bacillus no biocontrole de fitonematoides da soja. Logo, pode-se dizer que essas bactérias, quando bem posicionadas, podem contribuir significativamente para o manejo de nematoides fitopatogênicos em soja, sendo, portanto, ferramentas essenciais para um manejo estratégico e sustentável em ambientes agrícolas.
Confira o estudo completo desenvolvido por Reis e Oliveira (2025) clicando aqui!
Referências:
ARAÚJO, F. F.; SILVA, J. F. V.; ARAÚJO, A. S. F. INFLUÊNCIA DE BACILLUS SUBTILIS NA ECLOSÃO, ORIENTAÇÃO E INFECÇÃO DE Heterodera glycines EM SOJA. Ciência Rural, v. 32, n. 2, 2002. Disponível em: < https://www.scielo.br/j/cr/a/7rcT8Hdw3bwh5qmZsVmyw6y/?lang=pt# >, acesso em: 03/02/2026.
COELHO, T. N., et al. CONTROLE BIOLÓGICO NO MANEJO DE Pratylenchus brachyurus EM DIFERENTES TRATAMENTOS NA CULTURA DA SOJA. Journal of Biotechnology and Biodiversity, 2021. Disponível em: < https://sistemas.uft.edu.br/periodicos/index.php/JBB/article/view/11470/19047 >, acesso em: 03/02/2026.
COSTA, L. C. et al. DESENVOLVIMENTO DE CULTIVARES DE SOJA APÓS INOCULAÇÃO DE ESTIRPES DE Bacillus subtilis. Nativa, 2019. Disponível em: < https://periodicoscientificos.ufmt.br/ojs/index.php/nativa/article/view/6261/5390 >, acesso em: 03/02/2026.
INOMOTO, M. M.; ASMUS, G. L. CULTURAS DE COBERTURA E DE ROTAÇÃO DEVEM SER PLANTAS NÃO HOSPEDEIRAS DE NAMATOIDES. Visão Agrícola, n. 9, 2009. Disponível em: < https://www.esalq.usp.br/visaoagricola/sites/default/files/VA9-Protecao04.pdf >, acesso em: 03/02/2026.
REIS, C. M. R.; OLIVEIRA, R. M. TRATAMENTO DE SEMENTES DE SOJA COM Bacillus methylotrophicus PARA O MANEJO DE Meloidogyne javanica. Revista Cerrado Agrociências, 2025. Disponível em: < https://revistas.unipam.edu.br/index.php/cerradoagrociencias/article/view/5761/3386 >, acesso em: 03/02/2026.
Foto de capa: Cristiano Bellé




